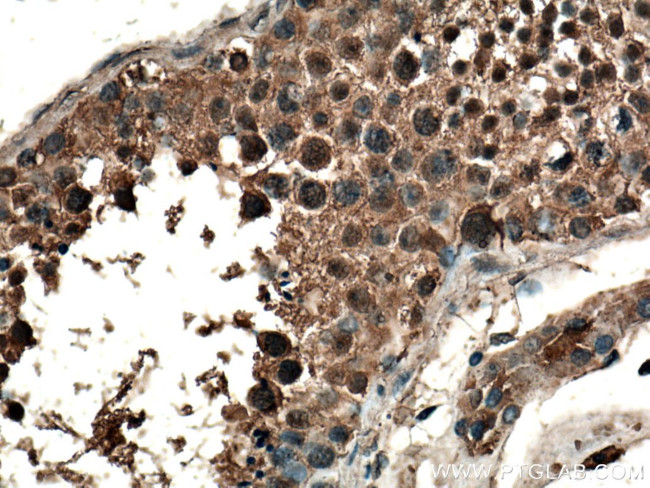
CLASP1 Antibody in Immunohistochemistry (Paraffin) (IHC (P))
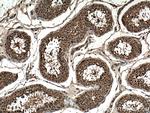
CLASP1 Antibody in Immunohistochemistry (Paraffin) (IHC (P))

Search
Proteintech
CLASP1 Polyclonal Antibody
{{$productOrderCtrl.translations['antibody.pdp.commerceCard.promotion.promotions']}}
{{$productOrderCtrl.translations['antibody.pdp.commerceCard.promotion.viewpromo']}}
{{$productOrderCtrl.translations['antibody.pdp.commerceCard.promotion.promocode']}}: {{promo.promoCode}} {{promo.promoTitle}} {{promo.promoDescription}}. {{$productOrderCtrl.translations['antibody.pdp.commerceCard.promotion.learnmore']}}
产品信息
20803-1-AP
种属反应
宿主/亚型
分类
类型
抗原
偶联物
形式
浓度
规格
纯化类型
保存液
内含物
保存条件
运输条件
产品详细信息
Immunogen sequence: MEPRMESCL AQVLQKDVGK RLQVGQELID YFSDKQKSAD LEHDQTMLDK LVDGLATSWV NSSNYKVVLL GMDILSALVT RLQDRFKAQI GTVLPSLIDR LGDAKDSVRE QDQTLLLKIM DQAANPQYVW DRMLGGFKHK NFRTREGICL CLIATLNASG AQTLTLSKIV PHICNLLGDP NSQVRDAAIN SLVEIYRHVG ERVRADLSKK GLPQSRLNVI FTKFDEVQKS GNMIQSAND (1-238 aa encoded by BC112940 )
靶标信息
CLASPs, such as CLASP1, are nonmotor microtubule-associated proteins that interact with CLIPs.
仅用于科研。不用于诊断过程。未经明确授权不得转售。
篇参考文献 (0)
生物信息学
蛋白别名: centrosomal; CLASP1-beta; microtubule- and kinetochore-associated protein; CLIP-associating protein 1; cytoplasmic linker associated protein 1; Cytoplasmic linker-associated protein 1; hOrbit1; multiple asters 1; Multiple asters homolog 1; Protein Orbit homolog 1; unnamed protein product
基因别名: 1700030C23Rik; 5730583A19Rik; B130045P17Rik; CLASP1; CLASP1alpha; KIAA0622; MAST1
UniProt ID: (Human) Q7Z460, (Mouse) Q80TV8
Entrez Gene ID: (Human) 23332, (Mouse) 76707, (Rat) 304740